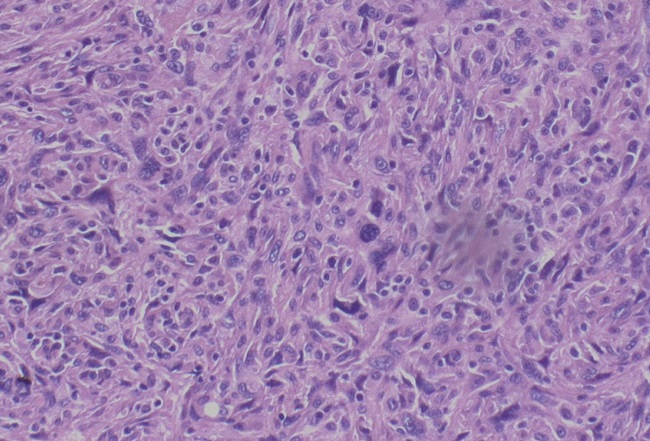
Neoplasia com predomínio de celulas fusiformes com nucleos de
							tamanhos variados e cromatina irregular

Relato de caso
Sarcoma pleomórfico indiferenciado: relato de caso
Undifferentiated pleomorphic sarcoma: a case report
Sarcoma pleomórfico indiferenciado: relato de caso
Surgical & Cosmetic Dermatology, vol. 12, núm. 1, Supl., pp. 92-95, 2020
Sociedade Brasileira de Dermatologia
Recepção: 31 Janeiro 2020
Aprovação: 13 Novembro 2020
RESUMO: Os sarcomas indiferenciados são neoplasias de tecidos moles derivados do mesoderma. Relatamos um caso de sarcoma pleomórfico indiferenciado, sua dermatoscopia, seu estadiamento e sua abordagem terapêutica.
Palavras-chave: Dermoscopia, Neoplasias de Tecidos Moles, Sarcoma.
ABSTRACT: Undifferentiated sarcomas are neoplasms of soft tissues derived from the mesoderm. We report a case of undifferentiated pleomorphic sarcoma, its dermoscopy, staging, and therapeutic approach.
Keywords: Dermoscopy, Sarcoma, Soft Tissue Neoplasms.
INTRODUÇÃO
Sarcomas são tumores derivados do mesoderma. São divididos em dois tipos: ósseos e de partes moles, em que se incluem os tumores cutâneos.1 Os sarcomas de partes moles acometem uma a cinco pessoas/100.000/ano, principalmente acima dos 55 anos.2 Seus subtipos principais são: gastrointestinal, lipossarcoma e leiomiossarcoma.2 Existem dois tipos de sarcomas de partes moles que mais comumente surgem na pele : sarcoma pleomórfico indiferenciado (antes denominado fibro-histiocitoma maligno pleomórfico e estoriforme) e mixofibrossarcoma (antes denominado fibro-histiocitoma maligno mixoide).1 Sarcomas cutâneos, geralmente, apresentam-se como nódulos cor da pele ou massas subcutâneas, de crescimento rápido, mais comumente nos membros.1
Há uma graduação histológica (G) para sarcomas de partes moles (FNCLCC- França) em que três parâmetros recebem uma pontuação: diferenciação (1 a 3), índice mitótico (1 a 3) e necrose tumoral (0 a 2). Com a soma dos números, encontram-se os seguintes resultados: GX, G1 (2 a 3), G2 (4 a 5), G3 (6 a 8). A American Cancer Society estabeleceu também um estadiamento TNM para este grupo de tumores a depender da sua topografia: cabeça e pescoço, tronco e extremidades, órgãos viscerais torácicos e abdominais e retroperitôneo3.
O sarcoma pleomórfico indiferenciado corresponde ao quarto mais importante sarcoma de partes moles. Sua epidemiologia é assim constituída: 50 a 70 anos (faixa etária mais acometida), com preponderância de homens (dois terços) em relação às mulheres quanto à prevalência.4 Membros inferiores são a topografia mais afetada, mas 10 a 15% ocorrem em cabeça e pescoço.1 Tendência evolutiva: recorrência local: 19 a 31%; índice de metástases: 31 a 35% (com a seguinte frequência: pulmões 90%, ossos 85%, fígado 1%). Taxa de sobrevida em cinco anos: 65 a 70%. O tratamento preconizado é cirúrgico com margens de 2cm e radioterapia adjuvante em casos selecionados (dificuldade de obtenção de margens livres pela cirurgia). Para a doença metastática indica-se quimioterapia (ainda que com resultados pobres) com antraciclinas (16 a 27% de resposta) associadas ou não à ifosfamida. Doxorrubicina é paliativa. Novos estudos têm mostrado maior benefício com mesilato de eribulina.5
RELATO DO CASO
Mulher, 88 anos, queixa-se de lesão nodular com crescimento progressivo na região clavicular esquerda há três meses. Exame dermatológico demonstrou tumoração violácea, ulcerada, com presença de necrose, friável, 11cm no maior eixo, na região infraclavicular esquerda (Figura 1). A dermatoscopia caracterizava-se por vasos polimórficos, sem outras especificidades (Figura 2). Realizada biópsia incisional da lesão, cujo exame anatomopatológico revelou infiltração da porção profunda da amostra por neoplasia de células grandes, de formato fusiforme predominante, com núcleos celulares de variados tamanhos e formas, com cromatina irregular; numerosas figuras de mitose, compatível com sarcoma fusocelular e pleomórfico infiltrado na derme reticular grau histológico 3 (Figura 3). O painel imuno-histoquímico apresentou resultado negativo para a expressão de todos os antígenos pesquisados (AE1/AE3, p63, 34BetaE12, proteína S-100, SOX-100, melan-A, AML, desmina, CD3 e CD34), compatível com sarcoma indiferenciado. Após exame anatomopatológico, optamos por exérese da lesão com margens cirúrgicas amplas e fechamento primário da ferida cirúrgica (Figura 4). Realizado rastreamento de metástases pulmonares, linfonodais e abdominais com exames de imagem, que foi negativo. A paciente encontra-se em seguimento, sem sinais de recidiva local (Figura 5).

DISCUSSÃO
Para estadiamento TNM deste caso foi adotada a referência da AJCC (American Joint Comittee on Cancer) 2018 para sarcomas de partes moles de tronco e extremidades. A Tabela 1 representa o T e o estadiamento final. o estadiamento final (repare que a classificação G descrita na introdução é considerada).
Neste caso relatado, a imuno-histoquímica foi de fundamental importância, uma vez que clinicamente e até histopatologicamente o sarcoma pleomórfico indiferenciado faz diagnóstico diferencial com:
- Melanoma (desmoplásico; positividade frequente para S100, HMW-MMA; rara positividade para SMA, desminina, fator XIIIA, laminina e colágeno tipo IV; e geralmente negativo para HMB-45, Gp100, melan A/Mart1, tirosinase e fator de transcrição de microftalmia).6
- Carcinoma espinocelular de células fusiformes (positividade para AE1/AE3, CAM5.2 e vimentina).7
- Dermatofibrossarcoma protuberans (positividade para CD34 e vimentina; negatividade para enolase neurônio específica, HMB-45 e proteína S100).8
- Fibroxantoma atípico (diagnóstico de exclusão, sendo negativo para citoqueratinas para excluir carcinoma espinocelular de células fusiformes, S-100 e marcadores melanogênicos, como melan-A e HMB-45 para excluir melanoma; desmina, actina e H- caldesmon para excluir leiomiossarcoma; e p63 e p40 para exclusão de carcinoma espinocelular.9
- Leiomiossarcoma (positividade para actina de músculo liso, desmina e S100).10
- Sarcoma pleomórfico indiferenciado (positivo para vimentina, fator XIIIa, CD68, CD10, CD34, CD 99; e negativo para marcadores de queratina, musculares e melanocíticos).11
CONCLUSÃO
O caso apresentado enriquece a memória do dermatologista quanto aos diagnósticos diferenciais possíveis dentre os raros tumores mesenquimais. Enfatizou-se o quão imprescindível é o papel da histopatologia e imuno-histoquímica, revisando-se o jogo de marcadores com suas correlações diagnósticas neste minidesafio e também trouxe a oportunidade de revisão de estadiamento e conduta de sarcomas de partes moles.
REFERÊNCIAS
Paiva A.C.G., Morgado A.M., Souza M.P. Undifferentiated pleomorphic sarcoma. An Bras Dermatol. 2018;93(1):154-5.
Staser K, Mount J, Solus C , Musiec A; Pleomorphic soft tissue sarcoma metastatic to the skin of the scalp and groin; JAAD case reports, march 2015.
Site da American Cancer Society : https://www.cancer.org/cancer/soft-tissue-sarcoma/detection-diagnosis-staging/staging.html
Salerni G; Dermoscopic findings in an early malignant fibrous histiocytoma on the face ; Dermatology Practical and Conceptual; 2017; 7(3) : 9
De Vita A. ,Recine F., Mercatali L. , Miserocchi G., Spadazzi C., Liverani C. , Bongiovanni A. , Pieri F. , Casadei R. , Nada Riva N. , Fausti V , Amadori D, Ibrahim T; Primary Culture of Undifferentiated Pleomorphic Sarcoma: Molecular Characterization and Response to Anticancer Agents Int. J. Mol. Sci. 2017, 18, 2662; doi:10.3390/ijms18122662
Paschoal FM, Yamada VL, Enokihara MMSS, Machado Filho CDS; Melanoma desmoplástico; Surg Cosmet Dermatol 2012;4(1):59-63.
Mitsuhashi et al.; Basosquamous and spindle cell carcinoma of the skin; J Cutan Pathol 2006: 33: 246-252; Copyright # Blackwell Munksgaard 2006.
Morais PM, Schettini APM, Chirano CA, Nakamura G; Tumor de Bednar (dermatofibrossarcoma protuberante pigmentado): relato de um caso, An Bras Dermatol. 2005;80(3):273-6.
Koch et al : Atypical Fibroxanthoma - Histological Diagnosis, Immunohistochemical Markers and Concepts of Therapy; Anticancer Research 35: 5717-5736 (2015).
Salgado LMR, Caetano LVN, Paula GM, Cysneiros MAPC, Fleury Jr LFF; Leiomiossarcoma cutâneo: relato de caso; Surg Cosmet Dermatol 2015;7(1):84-7.
Site de anatomia patológica da University of Washington: http://www.pathologyoutlines.com/topic/softtissuemfhpleo.html
Notas
Autor notes
Rebecca Silveira Revisão crítica da literatura.
Tatiane Benini Elaboração e redação do manuscrito; obtenção, análise e interpretação dos dados; participação intelectual em conduta propedêutica e/ou terapêutica de casos estudados; revisão crítica da literatura.
André Cesar Antiori Freire Pessanha Aprovação da versão final do manuscrito; concepção e planejamento do estudo; elaboração e redação do manuscrito; obtenção, análise e interpretação dos dados; participação efetiva na orientação da pesquisa; participação intelectual em conduta propedêutica e/ou terapêutica de casos estudados; revisão crítica da literatura; revisão crítica do manuscrito.
Correspondência: Centro Médico Pedra Verde R. Professor Leopoldo Paperini, 113 07095-080 Guarulhos (SP) E-mail: andrederma@hotmail.com
Declaração de interesses